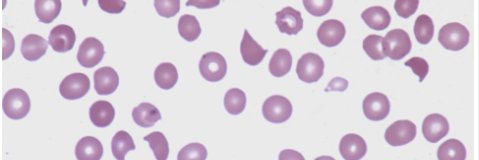
Autumn Jeong MD banner

Special issue on CAR T-cell therapy for lymphoma in the journal Cancers. Please consider submitting your amazing research!
mdpi.com/si/123546

English
Autumn Jeong MD
14 posts

@AutumnJeong
Hematology Fellow, Wife, and Mom



Help create the most important newspaper during #ASH22: ASH News Daily! Any ASH member can apply to be an author. ➡️Click here to learn more: loom.ly/Gfw_tgo






📧 The final core meeting day is here and ASH News Daily 🗞 has covered some of the top sessions presented yesterday like E. Donnall Thomas & Beutler. In this morning email @DrLizBrem @TaniaJain11 @PEllsworthMD @AaronGoodman33 & @AutumnJeong share their recaps. #ASH21
















⏰ 12:30 PM ET | #ASH21 🔬 Ham-Wasserman Lecture Dr. Andreas Trumpp will present the Ham-Wasserman Lecture on Normal and Leukemic #StemCells. #leusm

